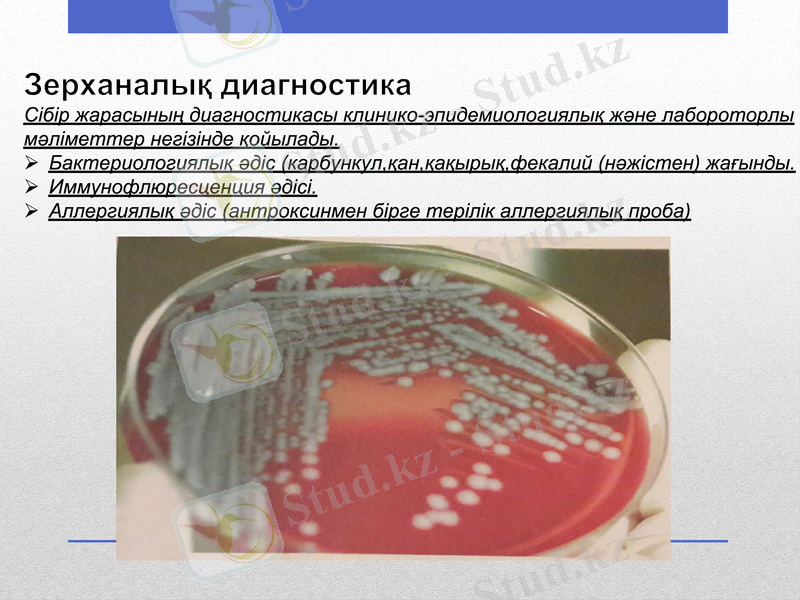
Slide 23

Сібір жарасы (Bacillus anthracis): қоздырғышы, эпизоотологиясы, клиникалық көрінісі және Қазақстандағы эпидемиологиялық жағдайы



Сібір жарасы
Қазақстан Республикасының Білім және Ғылым минстрлігі Семей қаласының Шәкәрім атындағы мемлекеттік университеті Аграрлық факультет Ветеринария кафедрасы
Орындаған: Тұрақова С. Ж
Тобы: ВС-503
Тексерген: Нуркенова М. К

Жоспар:
І. Кіріспе
ІІ. Негізгі бөлім
2. 1 Қоздырғышы
2. 2 Эпизоотологиясы
2. 3 Клиникалық көрінісі
2. 4 ҚР эпизоотиялық жағдайы
ІІІ. Қорытынды
ІV. Пайдаланылған әдебиеттер тізімі

Кіріспе
Сібір жарасы лат - Bacillus anthracis ) бактериалды зоонозды антропургиялық аса қауіпті, қоздырғышы қарым-қатынас (жанасу) механизмі арқылы берілетін, тері қабатының кабункул тәрізді зақымдалуымен, ауқымды ісікпен, ауыр интоксикациямен сепсистің дамуымен сипатталатын жұқпалы ауру.
Қоздырғышы - Bacillus anthracis ірі, грамм оң, капсула және спора түзетін, факультативті аэробты таяқша. Табиғатта екі түрде - вегетативті және спора түзген кезде кездеседі. Спора түрінде тек абиотикалық ортада ғана, ал вегетативті түрде тек жануарлар және адам организмінде болады. Спора түріндегі микробтар өте төзімді. Олар суда бірнеше жыл, топырақта бірнеше
ондалған жылдар бойыны сақтала алады. Споралар қолайлы қоректік, температуралық ылғалдылық жағдай туғанда көбейіп, қайта споралық күге ауыса алады. Сөйтіп абиотикалық ортада ошақтылықты сақтап тұрады. Споралар 120-140 °С құрғақ ыстықта 1-3 сағатта жойылады, автоклавта 180°С - 24 минутта, 1%формалин ерітіндісінде 2 сағатта жойылады, 4% хлораминнің белсіндірлген ерітіндісі, 6%сутегінің асқан тотығы спорациттік әсер етеді.

Қоздырғышы:
Қоздырғышы. Сыртқы ортаға төзімді келетін
таяқша тәріздес, Грам әдісімен, аналин
бояуларының барлық түрімен боялатын, капсула
түзетін аэробты микроб. Жер қыртысында өсіпөнеді
және спора түзеді. Топалан бацилласы
вегетативті түрде сыртқы ортаның әсеріне онша
төзімді емес, споралы түрі бұған керісінше өте
төзімді ж/е ұзак жылдар бойына тіршілік кабілетін
сақтайды. Сойылмаған бітеу өлікте ауру
қоздырғышы жаз кездері 1-3 тәулік ішінде кұрып
бітеді.
Топалаңнан өлген малды сойған кезде оттегінің
әсерінен қоздырғышы спораға айналатындықтан
мұндай малды жарып көруге қатаң тиым
салынады. Спора әр түрлі химиялық заттар мен
физикалык құбылыстарға аса төзімді, тіпті ол
тікелей түскен күн сәулесінен 4 күнге дейін өлмей,
шыдап баска, кайнаған суда 45-60 минутқа, 140
градусқа дейін қызған ауада 3 сағатқа, 1 пайыз
формалин мен 10 пайыз күйдіргіш натрий
ерітіндісінде 2сағатқа төзеді.

Эпизоотологиясы:
Эпизоотологиясы. Сібір жарасы өте кең тараған ауру. Оған ірі қара, қой, ешкі, жылқы, бұғы, түйе т. б. сондай-ақ жабайы шөп қоректілер шалдығады. Шошқа сирек, ит пен мысық бацилламен өте көп мөлшерде залалданғанда ғана ауырады.
Сақа жануарларға карағанда төл індетке біршама жиі шалдығады.
Сібір жарасы - маусымды індет. Ол әсіресе қуаңшылықты жылдары маусым-қыркүйек айларында жиі тарайды. Ауру қоздырғышы - індетке шалдыққан жануарлардың зәрі арқылы тарайды. Бұл індетпен өлген бүкіл органдары ұлпаларында бациллалар өте көп болады. Осы аурудан өлген хайуандарды сойып ішін жаруға болмайды.
Өйткені өлген немесе сойылған малдың терісі, еті, жүні т. б. арқылы індеттің ауру қоздырғышы сыртқы ортаға таралады. Қоздырғыштың таралуына ет қоректілер мен жыртқыш құстар да себепкер болады.
Сібір жарасы малға оларды ауру коздырғышымен ластанған жайылымдарға жайып баққанда, шөп, су аркылы тарайды. Індет негізінен жаз айларында өршиді. Малдың ауыз, жұткыншақ, кілегей қабықшаларындағы жарақаттар немесе ас қорыту жүйесіндегі ақаулар аурудың тарауына негізгі себеп болады.

Клиникалық көрінісі:
Бет-жақ аймағында, әдетте сібір жарасының жергілікті
шектелген (терілік) түрі дамиды. Ауру жәй, жалпы
көріністері байқалмай дамуы мүмкін, бірақ дене қызуы
38°-қа дейін көтеріледі. Ауру басталар алдында бет
терісінде қышитын түйіншек пайда болады. Оның
ортасында қанды бөртік, ал айналасында үлкен
инфильтрат дамып, жұмсақ тіндері домбығып ісінеді.
Бөртік өздігінен жарылып, инфильтраттың бетінде
қатты қара түсті қабыршақ пайда болады.
Қабыршақтың айналасынан сарысу шығып тұрады.
Инфильтрат айналасы білікті ісініп, түбі қарайған
жара пайда болады. Жараның айналасындағы
күлдіреген көпіршіктер жарылып 5-6 күннен кейін
көршиқан дамиды. Төменгі жақасты, иекасты және
мойын лимфа түйіндері үлкейіп, қатаяды. Сібір
жарасы немесе көршиқан инфекциясының күшейіп
асқынып, аурудың жағдайы нашарлап, дене қызуы
40°-қа дейін көтеріліп, организм улануының тағы да
басқа көріністерімен си-патталады. Жара ауыз
қуысының шырышты қабығына да шығуы мүмкін.

Қоздырғышы- Bacillus anthracis ірі, грамм оң, капсула және спора түзетін, факультативті аэробты таяқша. Табиғатта екі түрде-вегетативті және спора түзген кезде кездеседі. Спора түрінде тек абиотикалық ортада ғана, ал вегетативті түрде тек жануарлар және адам организмінде болады. спора түріндегі микробтар өте төзімді. Олар суда бірнеше жыл, топырақта бірнеше оңдаған жылдар бойыны сақтала алады. Споралар қолайлы қоректік, температуралық ылғалдылық жағдай туғанда көбейіп, қайта споралық күге ауыса алады. Сөйтіп абиотикалық ортада ошақтылықты сақтап тұрады. Споралар 120-140 С құрғақ ыстықта 1-3 сағатта жойылады, автоклавта 180 С -24 минутта, белсендірілген ерітіндісі, 6% сутегінің асқан тотығы спорациттік әсер етеді. Ол тұздалған теріде де тіршілік ете береді. Ауру қоздырғышы сыртқы ортада сапрофит ретінде өмір сүріп, шаң-тозаң, ағынды су, қан сорғыш кенелер арқылы бір жерден екінші жерге ауысып жанадан індет ошағын құрайды.
Этиологиясы

Адамдар мен жануарлардың жедел жұғатын жұқпалы індеті. Сібір жарасы-жіті жұқпалы ауру. Көбінесе тері жамылғысында көрініс береді, өкпе мен ішектерде сепсис түрінде өтуі-сирек кездеседі. Аурушаңдық Азия, Африка, Оңтүстік Америка елдерінде көп тараған. Оның ошақтары Ресей, Татарстан, Қазақстан және тағы басқа да елдерде бар. Қазақстан Республикасы аумағында соңғы 60 жыл ішінде 1700-ден астам сібір жарасы бойынша стационарлы-қолайсыз пункттер тіркелген.
Түйнеме

Адамдарға жұғу

Жиі ірі және ұсақ малдар, жылқы (60-85%)
Сирек шошқа, түйе, есе, жабайы жануарлар.
Жұқпа көзі және қоздырғыштың резервуары шөп коректі жануарлар (сиыр, жылқы, түйе, ешкі, қой, шошқа т. с. с) Жануарларда ауру негізінен ішектік және нәжісімен бөлінеді. Ауру мал заладылығын жазылғанша немесе өлгенше (80% дейін) сақтайды. Өлген малдың денесі 7 күнге дейін залалды, Ауру малдан алынған өнім (жүні, терісі, мүйізі т. б) көп жылдарға дейін қауіптілігін жоймайды. Ауру адамның эпидемиологиялық қауіптілігін аурудың клиникалық формаларына байланысты. Терілік формасы қауіпсіз саналады.
Инфекция көзі

Жанасу-тікелей жанасу арқылы жұғады; малға қарағанда, сойғанда, терісін сылағанда, етін өндегенде, жүн, тері жинап, өндегенде
Трансмиссивті-маса, қансорғыш шыбындардың шағуы арқылы жұғады.
Аспирациялы-ауа-шаң арқылы жүн, тері жинайтындар арасында кәсіптік ауру түрінде кездеседі.
Берілу жолдары:
Алиментарлы
Ауа-тамшы, ауа-шаң
Берілу факторлары
Біріншілік берілу факторлары-зәр, нәжіс, қан, ет, тері, жүн;
Екіншілік-саймандар, шөп, жем, т. с. с
5% жағдайда қоздырғыш адам организіміне аэрозольді немесе тағам жолымен енеді. Ауа-шаң (аэрогенді) жолы ауыл шаруашылық қызметкерлері арасында, техникалық қызметкерлер жүзеге асуы мүмкін.
Инкубациялық кезең:
Инкубация кезеңінің ұзақтылығы терілік формада бірнеше сағаттан 14 күнге дейін, сепсистік формада 6-8 күн.
Берілу механизмі:

Факторлары
Жастық- барлық топтарында кездеседі, көбіне ересек адамдар ауырады
Мерзімдік-жаз-күз
Жыныстық-ер кісілерде көп кездеседі.
Климаттық-географиялық-сібір жарасы мал шаруашылығы дамыған елдерде жиі кездеседі.
Қалалық-ауылдық-көбіне ауыл тұрғындары ауруға шалдығады
Кәсіптік- мал қожалығында жұмыс жасайтын адамдар ауырады

Қоздырғыш енген тері жамылғысында 2-3 күн өткен соң қызылтым немесе көкшіл түсті дақ пайда болады. Сол жер қышып, теріні сәл күйдіргендей болып басталып, үдей түседі. Бөртпе 12-24 сағат өткеннен кейін диаметрі 2-3 мм, ішінде ашық түсті сұйықтығы бар күлдіреген бөртпеге айналады, уақыт өте келе оның ішіндегі сұйықтық қою түске боялып, қан араласады. Бөртпе қышып шыдатпаған соң, ауруға шалдыққан адам оны қасып, бетін жаралап тастайды. Іріңді бөртпенің орнына беті ашылған өлі етті қабыршақ пайда болады. Дәл осы қабыршақ сібір жарасының негізгі белгісі, дерттің атауы да осы қара даққа («anthrax»-«углевик») байланысты шыққан. Қабыршақ қатты, тығыз, күйдірілген сияқты болады. Оның айналасын қызыл түсті жиек қоршайды.
Аурушаңдықтың клиникалық белгілері

Қазақстан Республикасындағы сібір жарасы бойынша эпизоотиялық жағдай талдауы анықталынған сау емес елді мекендер саны үнемі азаю тұрғысында өзгеріп келетінін көрсетті. Егер 2000 және 2001 жж. жалпы саны - 6 елді-мекен анықталса, 2003, 2004 және 2005 жж. тиісінше - 3, 2, және 1 сау емес елді мекен анықталған. Соңғы жылдары бұл ауру республика аумағында тіркелмеген. Аталған аурудың осыған ұқсас тұрғыда азайып өзгеру динамикасы байқалуда. Осылайынша, 2000 және 2001 жж. ауру коэффициенті тиісінше 0, 04 пен 0, 05 теңессе, 2002 ден 2004 жж. дейінгі аралықта ол 0, 01 құраған. Сау емес елді мекендер үлесі мен эпизоотиялық жағдайдың қауырттылық коэффициенті осы кезеңде 2000 және 2001 жж. 0, 08 -ден 2005 ж. 0, 01 дейін төмендеген.

Республика аумағын сібір жарасы бойынша аймақтарға бөлу
Облыс атауы, эпизоотиялық коэффициеті

ҚР өңірлеріне шаққандағы стационарлық-сау емес елдімекендер саны (1933-2012 жж. )

Маңғыстау, Атырау облыстарында көптеген жылдар бойы сібір жарасы ауруы болмауын олардың аумақтарының басым бөлігі сібір жарасы микробы үшін қолайсыз қоңыр және сұрғылт-қоңыр топырақты аймақтарда орналасуымен түсіндіріледі. Осы облыстардың басым бөлігін құмды аймақтар мен тұзды аймақтар алып жатыр, ал Маңғышылақта беткейінде қиыршықтасты жамлығысы бар ерекше сұрғылт-қоңыр түсті топырақты шағын аймақтар бар.

Қазақстан Республикасында 1961- 2009 жж аралығы кезеңінде ауылшаруашылық жануарлары арасында сібір жарасы тіркелуі. (Л. Ю. Лухнова мәліметтері бойынша)

Қазақстандағы сібір жарасы бойынша мезгілділік динамикасы
2006-2016

20
10
0
Қазақстан Республикасында 1997-2009ж жаралығы кезеңінде ауыл шаруашылық жануарлары арасында сібір жарасы тіркелуі.
(Л. Ю. Лухнова мәліметтері бойынша)

Кәсіптік-индустриальді
Тұрмыстық жағдай
Сібір жарасының сырқаттанушылығы
Кәсіптік-ауылшаруашылық

Сібір жарасының таралуы
Зерханалық диагностика
Сібір жарасының диагностикасы клинико-эпидемиологиялық және лабороторлы мәліметтер негізінде қойылады.
Бактериологиялық әдіс (карбункул, қан, қақырық, фекалий (нәжістен) жағынды.
Иммунофлюресценция әдісі.
Аллергиялық әдіс (антроксинмен бірге терілік аллергиялық проба)

Болжамы
Аурудың терілік түрі:Емі уақтылы басталмаса, өлім -жітім 2% . Емі мүлдем жасалмаса, өлім-жітім 20%.
Aурудың өкпелік түрі. Өлім-жітім өте жоғары. Уақтылы ем қабылданса да, өлім-жітім 90-95%
Аурудың асқазан-ішек түрі:Өлім-жітім 50%
Аурудың септикалық түрі:Өлім-жітім өте жоғары

1. Ошақтағы жасалатын шаралар.
- Іс жүргізу
- Автоматтандыру, Техника
- Алғашқы әскери дайындық
- Астрономия
- Ауыл шаруашылығы
- Банк ісі
- Бизнесті бағалау
- Биология
- Бухгалтерлік іс
- Валеология
- Ветеринария
- География
- Геология, Геофизика, Геодезия
- Дін
- Ет, сүт, шарап өнімдері
- Жалпы тарих
- Жер кадастрі, Жылжымайтын мүлік
- Журналистика
- Информатика
- Кеден ісі
- Маркетинг
- Математика, Геометрия
- Медицина
- Мемлекеттік басқару
- Менеджмент
- Мұнай, Газ
- Мұрағат ісі
- Мәдениеттану
- ОБЖ (Основы безопасности жизнедеятельности)
- Педагогика
- Полиграфия
- Психология
- Салық
- Саясаттану
- Сақтандыру
- Сертификаттау, стандарттау
- Социология, Демография
- Спорт
- Статистика
- Тілтану, Филология
- Тарихи тұлғалар
- Тау-кен ісі
- Транспорт
- Туризм
- Физика
- Философия
- Халықаралық қатынастар
- Химия
- Экология, Қоршаған ортаны қорғау
- Экономика
- Экономикалық география
- Электротехника
- Қазақстан тарихы
- Қаржы
- Құрылыс
- Құқық, Криминалистика
- Әдебиет
- Өнер, музыка
- Өнеркәсіп, Өндіріс
Қазақ тілінде жазылған рефераттар, курстық жұмыстар, дипломдық жұмыстар бойынша біздің қор #1 болып табылады.



Ақпарат
Қосымша
Email: info@stud.kz